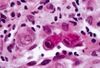

images/histology - julia Flashcards
(118 cards)
1
Q

A
- bacterial endocarditis
- little irregular blue things = inflammatory cells
- bottom right corner = fibrin
- smudgy blue material = masses of bacteria
1
Q

A
- liver with malaria
- breakdown products of Hb in Kupfer cells
2
Q

A
- inflammation in appendicitis
- way too many cells throughout
- epithelial surface being destroyed
3
Q

A
- bacterial endocarditis
- blue smudges = inflammatory cells or bacteria
- lighter pink = fibrin
- darker pink = collagen
3
Q
A
- cytomegalovirus
- cells become enlarged with huge intranuclear inclusions and cytoplasmic inclusions
4
Q

A
- acute pyelonephritis
- collecting tubule is the long thin thing full of PMNs in the middle/right of the image
- acute inflammatory infiltrate on right side
5
Q

A
normal small bowel
5
Q

A
* measles pneumonia
* interstital process
* airways don’t fill with inflammatory cells
* multinucleated giant cells scattered through the intestitum = typical marker of measles pneumonia
* most cells in the interstitium are lymphocytes, with some macrophages
5
Q

A
- amebic colitis in bowel
- higher magnification of edge of ulcer
- can see individual amebi
- look sort of like macrophages - round cells
6
Q

A
- biopsy of esophageal mucosa
- infected with CMV
enlarged endothelial cells with prominent intranuclear inclusions - stained by specific antibodies for CMV
- owl’s eye formation in center of enlarged cells
7
Q

A
- granuloma in lung due to TB
- can see langerhans giant cell in center of granuloma
8
Q

A
- serosal inflammation (right) and mucosal ulceration (left) in appendicitis
- superficial epithelium being sluffed off - mucosal ulceration
- too many little blue cells in serosa - inflammatory response
9
Q

A
- pneumonia
- alvolar wall thickening
- edema/fluid in alveoli
9
Q

A
- parasitized RBCs in small vessels of brain
- due to malaria
- each little dark dot = RBC full of malaria
10
Q

A
- aspergilis infection in lung vessels
- aspergilis is vasotropic, occludes and destroys walls
11
Q

A
- pneumonia
- cells with irregular nuclei = PMNs (they’re in the white space in the center)
- pink clumps (pale) = fibrin
- dark red = congested vessels
11
Q

A
- pap smear of patient with herpes
- inclusion bodies indicate herpes
11
Q

A
- HSV in lung or trachea
- big red inclusions
12
Q

A
- bowel
- mucosa at edge of ulcer due to amebic colitis
- mucosa being destroyed
12
Q

A
- lung
- respiratory syncytial virus
- cuase formation of syncytia = large groups of cells merged together
13
Q

A
- influenza pneumonia
- lung - large respiratory bronchial
- lymphocytes in the bronchial submucosa
- loss of superficial epithelium and fibrin in lumen
- epithelium sluffing off
- fibrin becuase there’s edema
- fibrin adhering to the airway - not filling up the air spaces
14
Q

A
- lung biopsy
- patient with mononuclear inflammation in interstitium
- too many nuclei in walls
- foamy material in airways = protein, pathogen, no inflammatory cells
15
Q

A
- liver
- most hepatocytes appear normal, but ducts dilated and have brown material in them
- bile has backed up into them
- due to swelling of pancreus => common bile duct gets compressed => back up of bile
16
Q

A
- lung infected with pneumocystis
- interstitial inflammation with foamy exudate in alveoli
17

normal skin
17

* peribronchial caseation
* caseation is on the left side - bland pink area
* due to granulomas joining, loss of blood supply
* later stage of continued infection of lung
18

* lung with abscess/empyema
* area of fibrin with mononuclear cells and micro-colonies
* dark purple dots = chronic inflammatory infiltrate
19

* adrenal gland disfunction due DIC
* hemorrhagic adrenal glands
* normal = tan yellow
20

* granulation tissue
* skin
* wound healing
* early stage
* loose watery material in background (pinkish material) = ECM = fibrin, fibronectin, collagen
* lots of inflammatory cells
* many tiny, thin-walled blood vessels
* big blue "angry looking" cells = highly activated fibroblasts- producing lots of ECM and laying down collagen
21

* bacterial endocarditis
* smudgy groups = bacteria (in top left corner)
* more distinct dark purple = PMNs = below bacteria and in large clear cleft
22

* caseation necrosis and fibrosis
* can't tell that this is lung (but was)
25

normal kidney
26

* RBCs infected with malaria
* ring form = condensed nuclear mass with ring of blue cytoplasm
27

* resolution of pneumonia
* restoration of archetecture by macrophage cleanup or inflammatory infiltrates
* in middle, most of cells are macrophages
* more or less normal archetecture of alveolar space
28

* keloid, skin
* dense collagen, lots of fibroblasts
* huge ropey-like fibers of collagen diffusely through the tissue
* will be a firm lesion
30

* ulceration and necrosis in appendicitis
* inflammatory infiltrate and destruction of tissue and necrosis
31

* consolidated lung (white area)
* lower lobe dense and not spongy
* due to pneumonia
32

* lung granuloma
* due to TB
* giant cell with multiple nuclei in center of granuloma
* lymphocytes = dark staining cells around boarder
* patch of epithelioid cells in bottom left of the granuloma (they're slightly darker pink) - these just look like epithelial cells - were originally of monocyte/macrophage origin
32

* zygomycosis
* note wide angle branching
* irregular, broad, nonseptate hyphae
33

* early scar on left, late on right
* trichrome stain - blue = fully formed collagen
* collagen in early not fully organized yet so doesn't stain blue
* so granulation tissue has only a few little wisps of blue
* also lots of dilated capiliareis in granulation tissue
33

* bowel with schistosome eggs and chronic inflammation
* villa nicely preserved
* on right, can see white spots = eggs
33

* lung with HSV infection
* thickend alveolar walls, but alveolar spaces still open
* lots of lymphocytes in walls - indicates that you're probably looking at something viral rather than bacterial
34

* india ink can't get into yeast (can't get through capsule)
* so can use to stain for yeast - yeast will be clear/white while everything around it will stain black
34

* gram stain of pseudomembrane
* contains budding yeast and pseudohyphae
* infected with candida albicans
* when this is in the oropharynx = thrush
* oval - budding yeast forms
* tubular structures are pseudohyphae
35

normal myocardium
36

* heart, 3-4 days after MI
* scaring process
* neutrophils virtually all gone
* macrophage predominant cell type
* some fibroblasts but "not in full swing of producing collagen yet"
* few little capillaries form
37

* \* measles pneumonia
\* interstital process
\* airways don't fill with inflammatory cells
\* multinucleated giant cells scattered through the intestitum = typical marker of measles pneumonia
\* most cells in the interstitium are lymphocytes, with some macrophages
39

* early pneumonia
* pink in alveolus = edema/serum
* all pink fluid came from endothelial vessels - begining to pull apart
* thin alveolar walls but thickening
40

* mononuclear inflammation of bowel wall due to thyphoid
* intracellular bacteria (though can't see them)
41

* kidney of patient with kidney failure due back pressure
* back pressure causes them to atrophy
* have chronic inflammation, fibrosis, glomeruli sclerosis
* renal tubules dilated, full of protein
42

* cervix of patient with herpes
* inclusion bodies indicate herpes - darker purple, larger spots
43

* interstitial pneumonia
* way too many cells
* many infammatory - expanding interstitium
* interstitial inflammation - results in "fluffy" inflitrates in xray
43

* lung in patient with DIC and fungal infection and pneumonia
* doesn't look anything like lung
* hemorrhagic necrosis = lots of cellular debris, fibrin, dead cells, branching mold
44

* brain with melanin stain (left) and silver impregnation techinque (right)
* cryptococcus makes tryptophan into pigement that's brown, very much like melanin
* on left, can stain for melanin to detect yeast
* can also use silver stain - silver molecules impregnate cell wall - will stain walls of any yeast
* can also see budding - identifies these cells as yeast
46

normal liver
47

* skin with purpuria
* fibrin platelet thrombi in small vessels
48

* brain
* necrosis of neurons and microgilal cells
* toxoplasma gondii encephalitis
* tiny dots = intracellular parasites (can't see well at this magnification)
50
what is this (connective tissue)?

* collage type I
* EM image
* most abundant type of collagen
* periodicity - lots of long extended cables - each cable made of three molecules wound together
51

* lung
* respiratory syncytial virus
* cuase formation of syncytia = large groups of cells merged together
52

* gram stain, lower respiratory sputum, pneumonia
* see PMNs (have mulitlobed bright red nuclei - in middle of image)
* pneumococci - little blue dots
53

* typhoid nodule in liver
* normal hepatocytes on boarders
* aggregation of mononuclear cells in center = typhoid nodule
* no neutrophils (doens't involved chemokines that bring in neutrophils)
54

* lung with HSV infection
* thickend alveolar walls, but alveolar spaces still open
* lots of lymphocytes in walls - indicates that you're probably looking at something viral rather than bacterial
55

* base of bowel ulcer due to amebic colitis
* high magnification so can see amebi
55

* brain of infant with HSV
* hemorrhage
55

* skin infected with pseudomonas folliculitis
* get lesion in hair follicle - microabscesses that consist of masses of neutrophils
57

* amebic colitis in bowel
* edge of ulcer - can see normal mucosa but at base all of the mucosa is gone, tissue being destroyed under the submucosa
58

* heart 24 hours after MI
* early scaring
* necrotic myocytes
* vast influx of neutrophils
* neutrophils themselves breaking down and degenerating as they release proteolytic enzymes, collagenases, etc. =\> digestion and removal of tissue
59

* lung on left - normal
* redish area = granulation tissue - used to be single layer of pleural cells
* purple area = cavity full of lymphocytes and inflammation cells
60

* base of ulcer in bowel due to amebic colitis
* mucosa and submucosa shredding
61

* aspergilis infection in lung vessels
* aspergilis is vasotropic, occludes and destroys walls
62

* septal renal infarct
* dark clump in center = bacteria
* dark blue dots = inflammatory infiltrate
* this was once an artery
* blocked by something carrying bacteria = infected infarction
62

* acute inflammation in pneumonia
* recruitment of PMNs - cells with irregular nuclei
* some cells with a little more cytoplasm - probably macrophages
* vessels very congested - huge numbers of RBCs in what should be very thin walls
* granular pink stuff = serous fluid has fibrinogen - being activated by coagulation cascade and forms clumps of fibrin
62

* aspergillosis (fungi)
* note 45 degree branching
* can see septate = little walls
* these differentiate this from zygomycosis, which won't have visible septae
64

* lung abscess and empyema
* liquefied cavity = dark purple in bottom left corner
* right region = fibrin, bacteria, inflammatory cells
65

* heart, mature scar tissue after MI
* trichrome stain
* can see collagen between myocytes
* after many months
66

* trachea with HSV infection
* mucosal epithelium has been lost
* cells where it has been maintained have cytopathic effect due to virus
68

* granulation tissue - skin
* wound healing, early stage
69

* aspergilis infection in lung vessels
* aspergilis is vasotropic, occludes and destroys walls
71

* dense dermal scar tissue in skin
* late stage of scar formation
* no inflammation
* virtually no blood vessels
* everything linear, nicely polymerized collagen
* very few and quiescent fibroblasts
* can take months to years
72

* small bowel of patient with typhoid
* inflammation that goes all the way through the bowel wall
* mononuclear inflammation within peyer's patches
72

* edge of emypema with granulation tissue and inflammatory cells
* on left, new vessels and fibrous tissue
* on right, dense chronic inflammation - mononucelar cells, plasma cells
72

* was once normal liver
* marked fribrosis surrounding schistosome granuloma
* all the pink stuff around the outside is collagen
* fibrosis has replaced the normal archetecture especially surrounding the veins, since that's how the eggs came in
74

normal lung
76

* pseudomembranous colitis associated with C. Diff
* form of nectritizing inflammation
* bowel
* with marked inflammation
* lesion like appearance of volcano
* pink stuff in pseudomembrane = fibrin
* also lots of inflammatory cells
* also bacteria there, but they're too small to see at this mag
77

* lung in patient with DIC and fungal infection and pneumonia
* doesn't look anything like lung
* hemorrhagic necrosis = lots of cellular debris, fibrin, dead cells, branching mold
78

* lung in patient with DIC and fungal infection and pneumonia
* doesn't look anything like lung
* hemorrhagic necrosis = lots of cellular debris, fibrin, dead cells, branching mold
* can see broad fungal hyphus in middle of image (dark purple and sort of wispy)
79

* cytomegalovirus
* cells become enlarged with huge intranuclear inclusions and cytoplasmic inclusions
81

* pseudomembrane
* pile of cellular debris, with bacteria, dead cells, fibrin
* due to C. diff
82

* granulation tissue - skin
* wound healing - early stage
* punch biopsy
* pit has become filled - lots of inflammatory cells, lots of very activated fibroblasts
83

* schistosome egg in bowel wall
* acute inflammation with eosinophils
84

* brain
* toxoplasma gondii encephalitis
* purple dots = intracellular parasites
85

* aspergilis infection in lung vessels
* aspergilis is vasotropic, occludes and destroys walls
86

* skin biopsy of lesion with infection
* only acute immune reaction because patient lacks neutrophils
* lots of gram negative rods - can see in the middle
88

normal heart valve
90

* acute inflammatory infiltrate in pneumonia
* macrophages have kidney shaped nucleus, a little more cytoplasm
* some RBCs, nucleus paler than the PMN nucleus
* PMNs = cells with the really dark blue irregular nuclei
91

* hepatic lesion
* granuloma and fibrosis
* schistosomia egg in middle
* light pink cells around it = epitheliod cells
* resembles TB granuloma (but develops differently =\> has more collagen)
93

* hyaline = clear
* influenza pneumonia
* not a cellular infiltrate filling up airspaces - hyaline
* interferes with normal oxygenation
* can be end product of viral action and all kinds of toxic things including high levels of O2
95

* bowel biopsy at high power
* CMV cells = enlarged cells with very dark staining nucli and sometimes can see nuclear inclusion = owl's eye cells
96

* trachea with HSV infection
* mucosal epithelium has been lost
* cells where it has been maintained have cytopathic effect due to virus
* inclusion bodies indicate herpes (look at darker spot in the middle of the white circle in the middle of the image)
97

* gelatinous appearance of cryptococcus in meninges in brain
* viscous so can block CSF circulation =\> hydrocephalous
98

* pancreas in patient with pancreatitis
100

* kidney with CMV infection
* owl eye cells
101

* cryptococcus in epidermis
* yeast = on right, white areas with dot in middle
* not much morphologic inflammation
102

* malaria in spleen (left) and liver (right)
* brown stuff is phagocytized breakdown products of Hb = characteristic of chronic malaria
104

* normal appendix
* lots of lymphocytes
105

* kidney infection
* with CMV - can see dark large cells but most of kidney looks normal at this magnification
106

* HSV in lung or trachea
* big red inclusions
107

* skin wound in the process of scar formation
* reepitheilalized
* will become focus of scar
* vascularity and cellularity will decrease over time - this about 1-2 months old
108

* lung
* CMV pneumonia
* great big cells with very dark nuclear staining = CMV infected cells
* sometimes can actually see rim of nucleus with inclusion within it
109

* pyelonephritis
* lots of PMNs
* glomerulus/structure visible
* glomerulus not really involved
110

* yeast stained with mucicarmine stain - dyes capsules bright pink
* brain
* diagnostic characteristic of crytpococcus
111

* candida albicans invading epithelium
* yeast-like oval forms, some with tubular structures
112

* heart 4-7 days after MI
* early myocardial granulation tissue
* still inflammatory cells and macrophages
* lots more background ECM
* fribroblasts prominent, large, active
* lots of capillaries formed
* stage will persist for weeks
114

* kidney with CMV infection
* see cytomegalic cells in the collecting tubules (epi cells)
115

* skin biopsy - low power
* of a lesion
* purple at the top are the squamous epithelium
* can see hair follicles and vessels
* brown stuff is india ink (not important - just used to help the pathologists remember the orientation of the sample)
* there's reduced acute inflammation with bacterial pathogen in this - reduced because the patient has low neutrophil count
116

* phagocytized yeast in lung nuclei
* macrophages
* little lighter dots in cytoplasm = yeasts
* halo around yeasts = polysaccharide capsule
117

* lung with HSV infection
* thickend alveolar walls, but alveolar spaces still open
* lots of lymphocytes in walls - indicates that you're probably looking at something viral rather than bacterial
118

* heart 4-8 weeks after MI
* maturing granulation tissue
* inflammatory cells virutally all gone
* ECM no longer watery, begining to organize
* blood vessels far more defined


